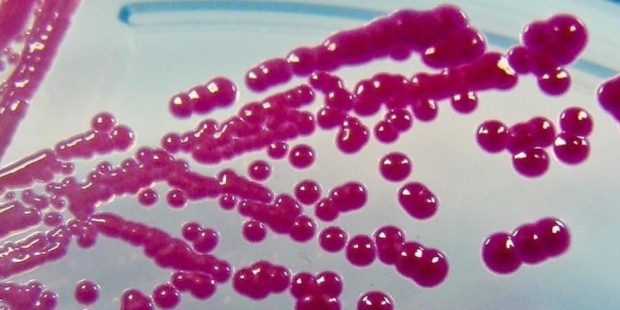
عملیات Sea Spray

در سالهای آغازین جنگ سرد، نیروی دریایی آمریکا عملیات محرمانه Sea Spray را روی شهر سانفرانسیسکو انجام داد که فاجعهای بیولوژیکی را رقم زد.
در میانه قرن بیستم، جهان در زیر سایه سنگین جنگ سرد نفس میکشید و ترس از حمله ناگهانی دشمن و رقابت بیامان قدرتهای شرق و غرب، هر جنبهای از زندگی بشری را تحتتأثیر قرار داده بود. موج توسعه تسلیحات در آن دوران، تنها به زرادخانههای اتمی محدود نبود و ایالات متحده و اتحاد جماهیر شوروی همزمان به ساخت و آزمایش ابزارهای غیرمتعارف شامل عوامل شیمیایی و سلاحهای بیولوژیکی روی آوردند تا توان تخریب و بازدارندگی خود را گسترش دهند.
در چنین فضایی، نظامیان آمریکایی به دنبال درک میزان آسیبپذیری شهرهای خود در برابر حملاتی با منشأ میکروبی بودند؛ طرحهایی محرمانه که زیر عنوان برنامههای تحقیقاتی امنیت ملی طبقهبندی شدند. یکی از پرسروصداترین این پروژهها، عملیات Sea Spray (اسپری دریایی) بود که در سپتامبر سال ۱۹۵۰ توسط نیروی دریایی آمریکا بر فراز شهر سانفرانسیسکو انجام گرفت.
آغاز سایههای جنگ بیولوژیک در عملیات Sea Spray
برای فهم چرایی عملیات Sea Spray، باید به فضای پرتنش سالهای پس از جنگ جهانی دوم بازگردیم. در این دوره جهان در میان رقابت ایدئولوژیک و نظامی آمریکا و شوروی گرفتار شده بود و قدرتهای بزرگ نهتنها در توسعه بمبهای هستهای و موشکهای بالستیک پیشروی میکردند، بلکه حوزههای تازهای از جنگ، از جمله سلاحهای بیولوژیک و شیمیایی وارد عرصه رقابت شدند. تجربه تلخ استفاده از گازهای سمی در جنگ جهانی اول و مطالعات جدید درباره میکروبها و ویروسها به ارتشها نشان داد که میتوان از میکروارگانیسمها نهفقط برای درمان، بلکه برای نابودی استفاده کرد.
ایالات متحده که در آن زمان خود را در جایگاه قدرت برتر جهانی میدید، نگران بود مبادا دشمنان از این نوع سلاحها برای حمله به شهرهای پرجمعیت استفاده کنند. از همین رو ارتش و نیروی دریایی آمریکا مجموعهای از پروژههای محرمانه آزمایش دفاع بیولوژیک را آغاز کردند تا میزان آسیبپذیری شهرهای خود را بسنجند. این طرحها زیر عنوان کلی «آزمایشهای پخش هوابرد» دستهبندی میشدند.
عملیات Sea Spray یا «اسپری دریا»، یکی از سریترین آزمایشهای بیولوژیکی تاریخ ایالات متحده بود که بهصورت رسمی در روزهای پایانی سپتامبر ۱۹۵۰ اجرا شد. برای این منظور، سانفرانسیسکو با موقعیت جغرافیایی خاص خود شامل جریانهای دائمی باد، رطوبت بالا و تراکم جمعیت، مکان مناسبی برای آزمایش و شبیهسازی رفتار مواد آئروسل تشخیص داده شد.
کشتی نیروی دریایی USS George Eastman در نقطهای از ساحل شمالی استقرار یافت تا از مسیر بادهای ساحلی استفاده کند و ابر میکروبی آزمایشی را بهسوی مناطق مرکزی شهر و حتی حومهها هدایت کند. تجهیزات پخش بر اساس طراحی محرمانهای ساخته شده بود که قادر بود ترکیبی از دو گونه باکتریایی Serratia marcescens و Bacillus globigii را بهصورت ذرات بسیار ریز در هوا منتشر کند. Serratia بهعلت رنگدانه قرمزرنگ برای ردیابی آسان انتخاب شد و Bacillus globigii بهعنوان نمونهای شبیهساز غیرعامل سیاهزخم، پایداری و دوام آئروسلها را بازنمایی میکرد.
فرآیند پخش در چندین نوبت و طی چند روز انجام گرفت تا دادههایی از شرایط مختلف دما، باد و رطوبت جمعآوری شود. برای سنجش نتایج، دهها ایستگاه نمونهبرداری روی ساختمانهای دولتی، تجاری و حتی اسکلهها نصب شد. این ایستگاهها با فیلترهای ویژه، ذرات موجود در هوا را جذب کرده و به آزمایشگاههای نظامی ارسال کردند. تحلیلها نشان داد که مواد میکروبی در سراسر محدوده شهری بهطور مؤثر پخش شدهاند و در نقاط ساحلی و مراکز تجاری، تراکم آنها به بالاترین حد رسید.
ابر میکروبی خطرناک بر فراز سانفرانسیسکو
در گزارشهای همان سال آمده است که ابر میکروبی توانسته جمعیتی حدود ۸۰۰ هزار نفر را در معرض ذرات قرار دهد که برای زمان خود شگفتانگیز محسوب میشد و از دید فرماندهان، موفقیتی فنی بود. اما تنها چند روز بعد نشانههایی از پیامدهای واقعی آشکار شد. بیمارستان استنفورد مواردی از عفونتهای نادر ناشی از Serratia marcescens گزارش کرد.
یکی از بیماران، مردی ۷۵ ساله به نام ادوارد جی. نوین، دچار عفونت خون شد و با وجود تلاش پزشکان جان خود را از دست داد. در آن زمان هیچکس منشأ این بیماریهای غیرمعمول را نمیدانست و ارتش نیز سکوت اختیار کرد. محرمانهبودن پروژه سبب شد تا حتی مقامات بهداشت عمومی از واقعیت بیخبر بمانند. از منظر نظامی، این بیخبری دقیقاً بخشی از آزمایش بود و ارتش میخواست رفتار طبیعی جامعهای بیاطلاع را در مواجهه با آلودگی گسترده بسنجد.
اما از دید اخلاقی همین ناآگاهی برنامهریزیشده نهفقط شهروندان، بلکه اصول انسانی پژوهش را زیر سؤال برد. اسناد این عملیات تا دو دهه بعد کاملاً پنهان ماند و تنها در دهه ۱۹۷۰، پس از افشاگریهای رسانهای و جلسات کنگره جزییات آن آشکار شد. کمیتههای مستقل پزشکی بعدها هشدار دادند که انتشار عمدی باکتریها بدون رضایت عمومی، حتی اگر عامل بیماریزا خفیف باشد، تخطی جدی از حقوق انسانی است.
با این حال نتایج فوری از دید فرماندهان نظامی موفق بود و دادهها نشان دادند که یک عامل میکروبی میتواند در کمتر از چند ساعت سطح یک کلانشهر را پوشش دهد و در فاصلهای وسیع گسترش یابد. اما این موفقیت ظاهری، در سالهای بعد چهرهای دیگر پیدا کرد و به یکی از نمونههای شاخص سوءاستفاده علمی از مردم غیرنظامی بدل شد.
فاش شدن حقیقت Sea Spray پس از سکوتی بیستساله
بیش از بیست سال، عملیات Sea Spray در تاریکی مطلق و میان لایههای محرمانه دولت آمریکا پنهان ماند. خانوادههای قربانیان از جمله بازماندگان ادوارد جی. نوین هیچگاه تصور نمیکردند که مرگ وی ممکن است حاصل یک آزمایش نظامی برنامهریزیشده باشد. در تمام آن سالها، این حادثه در پروندههای رسمی بیمارستانها با عنوان «عفونت نادر با منشأ نامشخص» ثبت شده بود و هیچ نهاد مدنی یا پزشکی تردیدی نسبت به دخالت دولت مطرح نکرد.
این سکوت سنگین تا اوایل دهه ۱۹۷۰ ادامه یافت و سرانجام تحقیقات گسترده کنگره ایالات متحده درباره آزمایشهای بیولوژیک داخلی آغاز شد. در جریان این جلسات، مجموعهای از اسناد طبقهبندینشده و شهادتهای افسران بازنشسته منتشر شد که بسیاری را شوکه کرد. رسانهها برای نخستینبار از وجود پروژههایی پرده برداشتند که هدفشان شبیهسازی حملات بیولوژیک به شهروندان آمریکایی و بدون اطلاع رسانی عمومی بود.
گزارشهای رسمی وزارت دفاع در سال ۱۹۷۶ نشان داد بین سالهای ۱۹۴۹ تا ۱۹۶۹، بیش از ۲۰۰ آزمایش مشابه در شهرهای مختلف از جمله نیویورک، واشنگتن و نروک انجام شده است. در میان این طرحها عملیات Sea Spray جایگاه ویژهای داشت، زیرا در مقیاس یک کلانشهر و با جمعیتی بیش از 800 هزار نفر اجرا شد. روزنامههایی همچون واشینگتن پست و نیویورک تایمز تیتر زدند: «شهروندان، آزمایششدههای بیخبر جنگ سرد»، و کانالهای تلویزیونی با دعوت از پزشکان، سیاستمداران و متخصصان ساعتها درباره خطرات چنین آزمایشهایی بحث کردند.
برخی دانشمندان هشدار دادند که Serratia marcescens گرچه برای افراد سالم اغلب بیخطر است، اما میتواند برای سالمندان، بیماران بستری یا افراد دارای نقص ایمنی مرگبار باشد. در پی انتشار این گزارشها، خانواده نوین شکایتی حقوقی علیه دولت آمریکا تنظیم کردند. آنها خواستار غرامت و پذیرش رسمی مسئولیت شدند، اما بهدلیل نبود اسناد قطعی و دشواری اثبات رابطه مستقیم میان انتشار باکتری و مرگ، دادگاه به نفع دولت رأی داد.
با این وجود، پرونده ادوارد جی. نوین به سمبلی از نبرد شهروندان با سکوت ساختارهای قدرت تبدیل شد و در حافظه تاریخی آمریکا ماندگار گشت. موج اعتراضات افکار عمومی در نهایت موجب شد چارچوبهای قانونی تازهای برای انجام پژوهشهای انسانی تدوین شود. از آن پس، نهادهای نظامی و علمی آمریکا ملزم شدند هر تجربهای را که احتمال در معرض قرار دادن انسانها دارد، زیر نظر کمیتههای مستقل اخلاق انجام دهند.
میراث جهانی عملیات اسپری دریا
افشای اسناد محرمانه عملیات Sea Spray در دهه ۱۹۷۰ تنها یک رسوایی علمی یا نظامی نبود، بلکه نقطهٔعطفی در تاریخ برخورد میان دانش، اخلاق و قدرت سیاسی محسوب میشود. تا پیش از آن در فضای پرتنش جنگ سرد، بسیاری از آزمایشهای نظامی و حتی پزشکی به نام امنیت ملی بدون رضایت یا اطلاع افراد انجام میگرفت و این باور وجود داشت که هدف جمعی میتواند بر حقوق فردی برتری داشته باشد. اما زمانی که آشکار شد شهروندان سانفرانسیسکو در سال ۱۹۵۰ بیخبر از همهچیز در معرض آئروسلهای حاوی باکتری قرار گرفتهاند، این فرض دیرینه فرو ریخت.
خشم افکار عمومی و فشار رسانهها دولت را وادار کرد تا در کنگره آمریکا کمیتههایی ویژه برای بررسی مرزهای اخلاقی پژوهشهای انسانی تشکیل شود. همزمان، افشای دیگر پروندههای تلخ مانند مطالعه سیفلیس در تاسکیگی و آزمایشهای تشعشعی روی شهروندان بیاطلاع، بستر اعتراضات شدیدتری را فراهم کرد. در نتیجه دولت ناچار شد نظام نظارتی تازهای را پایهگذاری کند.
یکی از بنیادیترین دستاوردهای این دوره، تدوین اصل «رضایت آگاهانه» بود که بعدها به ستون اخلاق پژوهش بدل شد و در اسناد بینالمللی از جمله «اعلامیه هلسینکی» جایگاه دائمی یافت. بر اساس این اصل هیچ فردی نباید پیش از آنکه از هدف، خطرات و پیامدهای آزمایش مطلع شود، در معرض مطالعه قرار گیرد. از دیدگاه اخلاق علمی، عملیات Sea Spray نمونهای بارز از نقض احترام به شخصیت انسان، توازن سود و زیان و عدالت در توزیع خطر محسوب میشود.
شهروندان سانفرانسیسکو بدون هیچ اطلاع یا انتخابی در معرض عامل میکروبی قرار گرفتند و حتی اگر هدف ارتش صرفاً شبیهسازی یک حملهٔ بیولوژیک بوده، حقیقت آن است که مرز میان آزمایش دفاعی و تعرض به جمعیت غیرنظامی به طرز خطرناکی محو شده بود. پیامدهای این حادثه، فراتر از جنبه اخلاقی، عرصه سیاست و حقوق را نیز تحت تأثیر قرار داد. وزارت دفاع آمریکا پس از انتشار اسناد، اجرای بخشی از برنامههای آزمایش میدانی را متوقف کرد و تصمیم گرفت تمامی تحقیقات مرتبط با عوامل بیولوژیک فقط در محیطهای کنترلشده انجام شود.
در سطح فدرال نیز مقررات سختگیرانهای برای مستندسازی، گزارشدهی و نظارت بر هرگونه فعالیت مرتبط با عوامل بیماریزا وضع شد، هرچند بسیاری از منتقدان معتقد بودند این اصلاحات همچنان ناکافی است و تضمین کامل برای جلوگیری از تکرار چنین فجایعی وجود ندارد. همزمان در صحنه بینالمللی، موج افشای عملیاتهای مشابه باعث شد فشار جهانی بر ایالات متحده برای پیوستن به «کنوانسیون سلاحهای بیولوژیک» در سال ۱۹۷۲ افزایش یابد. این پیمان، نخستین توافق چندجانبه بود که استفاده از عوامل میکروبی بهعنوان سلاح را ممنوع اعلام کرد.
چگونه Sea Spray مرز میان علم و انسانیت را ترسیم کرد؟
بیش از هفتاد سال از اجرای عملیات Sea Spray میگذرد، اما این رویداد همچنان در کتابهای تاریخ علم و اخلاق پژوهش بهعنوان نمونهای هشداردهنده تدریس میشود و یادآور دورانی است که مرز میان پیشرفت علمی و نقض حقوق انسانی به خطرناکترین شکل ممکن درهم آمیخت. هرچند جهان امروز با استانداردهای دقیق ایمنی، فناوریهای پیشرفته و نظامهای نظارتی گسترده فاصلهای عظیم با دهه ۱۹۵۰ دارد، اما بیتوجهی به رضایت و حقوق مردم در پژوهشهای علمی میتواند اعتماد عمومی را برای دههها از میان ببرد.
در سانفرانسیسکو، جایی که شهروندان بیخبر در معرض آئروسلهای میکروبی قرار گرفتند، این حادثه به بخشی از حافظه جمعی بدل شده است. نویسندگان، مستندسازان و روزنامهنگاران بارها آن را بازگو کردهاند تا واقعیتی فراموششده را زنده نگه دارند که نشان میدهد حتی در جوامع دموکراتیک، قدرت و امنیت ملی میتوانند بهانهای برای تجاوز به کرامت انسانی شوند.
برخی از بازماندگان و خانوادههای قربانیان همچنان بر یادآوری آن پافشاری میکنند و از نسلهای بعد میخواهند درس عملیات Sea Spray را هیچگاه از ذهن و وجدان خود پاک نکنند. افشای این عملیات در دهه ۱۹۷۰ پرده از یکی از محرمانهترین آزمایشهای بیولوژیک زمان خود برداشت و خیلی زود در اسناد رسمی، آییننامههای فدرال و مقررات بهداشتی ایالات متحده جای گرفت و امروزه بخشی از چارچوب قانونی برای تضمین ایمنی شهروندان در برابر پروژههایی است که میتوانند فارغ از اطلاع عمومی اجرا شوند.
با این حال، کارشناسان امروز هشدار میدهند که نبود شفافیت کامل در برخی طرحهای امنیتی و تحقیقاتی میتواند زمینهساز تکرار چنین رویدادهایی در قالبهای نو باشد. تاریخ نشان داده است که پیشرفت علمی اگر از نظارت اخلاقی جدا شود، بهسرعت میتواند از مسیر انساندوستی منحرف گردد و اعتماد جامعه را از بین ببرد.
از منظر علم و تاریخ، Sea‑Spray دو چهره متضاد دارد و از یکسو تجربهای میدانی است که نشان میدهد چگونه دادههای زیستمحیطی دقیق از محیط شهری قابل استخراج هستند و از سوی دیگر یادآور این حقیقت است که هیچ دادهای، هرچقدر هم دقیق در غیاب اخلاق و رضایت انسانی ارزش و مشروعیت ندارد. این دوگانگی، عملیات Sea Spray را به همزمان به عنوان یک «نمونه پژوهشی» و یک «هشدار اخلاقی» در تاریخ علم ثبت کرده است.
میراث این عملیات نهتنها در حوزه پژوهشهای انسانی، بلکه در فلسفه امنیت و سیاست نیز زنده است. امروزه هرگاه سخن از پروژههای دفاعی، آزمایشهای انسانی یا تحقیقاتی میرود که بر مرز میان سلامت عمومی و منافع ملی حرکت میکنند، نام Sea‑Spray همچون سایهای هشداردهنده یادآور میشود که علم و امنیت باید همیشه زیر چتر شفافیت، پاسخگویی و احترام به کرامت انسان بمانند.
گجت نیوز آخرین اخبار تکنولوژی، علم و خودرو